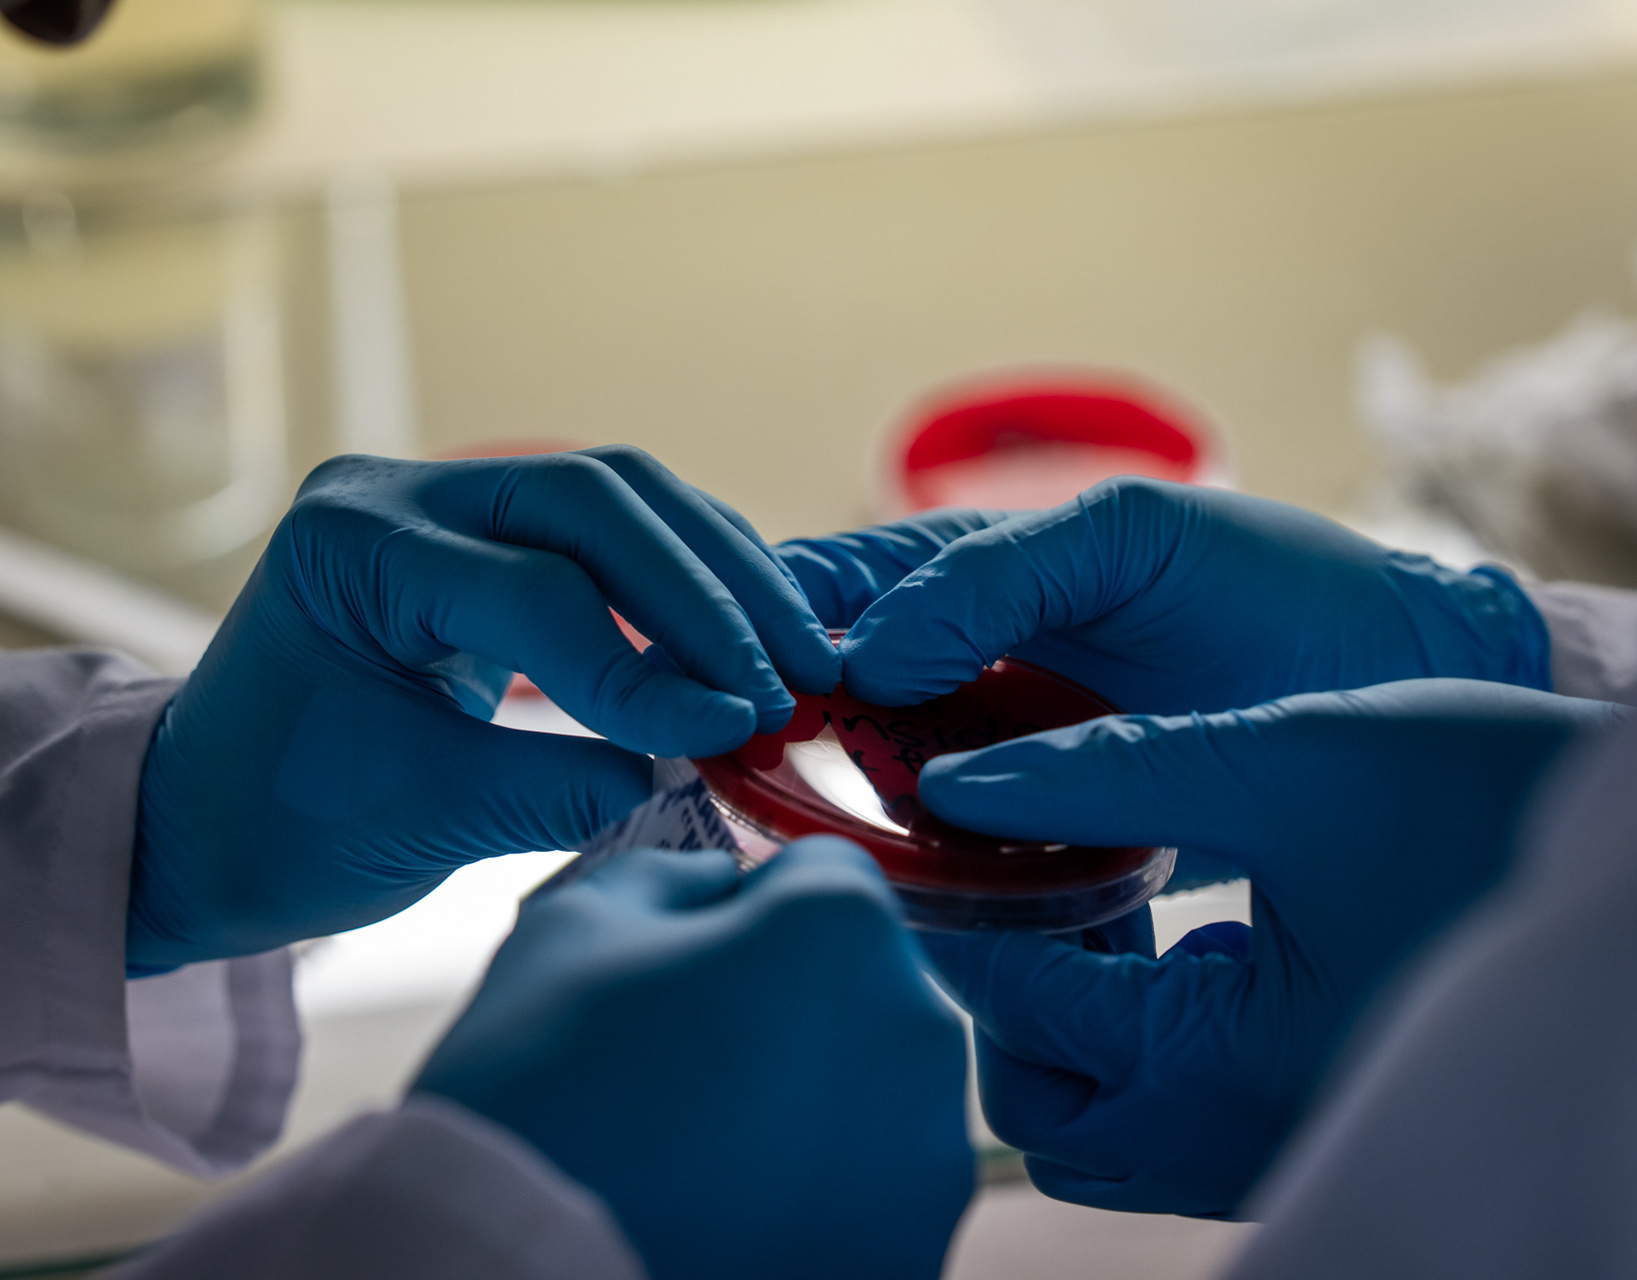

ABOUT

MOTHERS AT RISK
PREGNANT AND FIGHTING TB | 2025

MEDIA WORKSHOPS
IKAMVAYOUTH | 2025

ASHES OF HOMES
THE FIRE WAS COMING TOWARDS ME | 2025
SCIENCE WORKSHOPS
IKAMAVAYOUTH | UCT | 2025

WHAT CAUSES TB?
TB BASICS | 2022

BULUNGULA INCUBATOR
YOUTH FILM PROJECT | EASTERN CAPE | 2024

POETRY SESSIONS
FIRST FRIDAYS | 2025

LEARNER FILM
ALCOHOL SURVIVOR | 2024

EH!WOZA YOUTH
YOUTH HEALTH WORKSHOPS | 2024

WORLD TB DAY
ISIVIVANA | KHAYELITSHA | 2025

WHAT IS ANTIMICROBIAL RESISTANCE
AMR PART 1 | 2024

SHOOT DAYS
EH!WOZA HIGH SCHOOL LEARNER DOCUMENTARY FILMS PROJECT | 2022

EPIC STORIES UNTOLD
A$CII DAGGER | 2022

WHAT DO WE KNOW ABOUT TB?
TB BASICS | 2022

TOGETHERNESS
INNOCENT MUZIQ | 2020

DONATE

PARTNERS